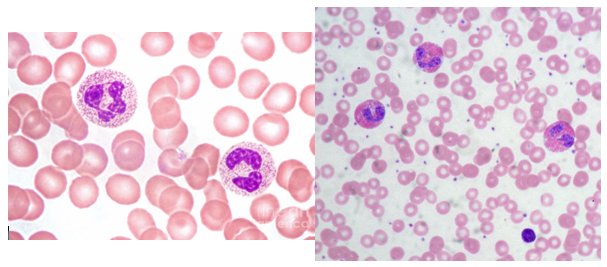

What is acute inflammation?
Rapid non-specific response to cellular injury. Orchestrated when cells release mediators and leukocytes and vascular system responds.
What is chronic inflammation?
Persistent inflammatory response. Ongoing inflammation and may arise from acute inflammation. In an attempt to heal damage.
Cardinal signs of acute infection? (x5)
Rubor (redness) Calor (Heat) Tumor (swelling) Dolor (pain) Fifth feature that some say, is loss of function.
What are the three stages of acute inflammation? Link with the cardinal signs.
- Increased blood flow (explains why red and hot). 2. Structural change to the microvasculature to allow proteins and leukocytes to leave circulation (swelling). 3. Emigration, accumulation and activation of leukocytes at focus of injury. Action of leukocyte = pain.
What are the mediators and what do they do in the acute inflammatory response?
Induced by several mediators including HISTAMINE and nitric oxide which affect smooth muscle and induces vasodilation. CYTOKINES are responsible for endothelial activation and attracting leukocytes to the site.
What happens to flow over the site in acute inflammation? (x2 points)
Results in vasodilation which INCREASES FLOW and increased permeability. Leakiness and increased diameter means that flow is slower - leads to stasis (inactivity) over site of inflammation which can be useful for making sure everything is there for dealing with the injury.
Where is histamine MAINLY released?
Mast cell is major source of histamine.
What is the mechanism for increased vascular permeability? Name of process?
Endothelial cells CONTRACT, so increased interendothelial spacing (holes). Called Immediate Transient Response.
What causes vascular leakiness? (x1 for I-T Response, and x3 for other explanations)
Histamine and other chemicals produces immediate transient response. BUT, IT MAY NOT ALWAYS BE ENDOTHELIAL CONTRACTION THAT LEADS TO LEAKINESS… Endothelial cell injury. Leukocyte-mediated cell injury (late stage inflammation). Leukocyte can produce additional signals for leakiness. VEGF increases transfer of materials across cells.
What is an exudate?
Materials that have seeped out of blood vessels that shouldn’t have e.g. proteins and cells.
Examples of exudate? (x2) [Not needed but helps understanding.]
Blister liquid (quite watery) and pus (lots of cells).
What are the main leukocytes in the acute inflammatory response?
Initially, the most important leukocytes are those capable of phagocytosis: NEUTROPHILS and MACROPHAGES. NEUTROPHIL is by far the main one!!! What do leukocytes GENERALLY do and how is their response delivered? Leukocytes recognise microbes and necrotic tissue with receptors and are activated. Kill bacteria and eliminate necrotic material. Also produce multiple factors and mediators that interact with other cells.
What are the roles of neutrophils? (x3)
Phagocytosis. Recruit additional cells. Degranulation (secrete enzymes, free radicals, soluble mediators).
What makes the acute inflammatory response terminate? (x4)
Mediators and neutrophils have short half-life. Macrophages release anti-inflammatory products. Mast cells and lymphocytes produce anti-inflammatory products like Lipoxins. The cause of the injury is removed.
How can an acute infection be identified histologically?
Vessels filled thickly with blood. Dense cloud of neutrophils can be seen. Would also be able to see Eosinophils and mast cells.
1st Photo = neutrophil
2nd photo = eosinophil
Causes of chronic inflammation? (x4)
Persistent infection. Prolonged exposure to toxins (endogenous or exogenous), so inflammatory response never has the chance to remove the harmful specimen – which of course is its aim. Autoimmunity. Foreign body may be hard to remove e.g. silica.
What is a chronic inflammation characterised by? (x3)
Tissue destruction. Persistent inflammation. Attempts at healing by replacement of damaged tissue with CONNECTIVE tissue. All occur simultaneously.
What cells are involved in the chronic inflammatory response? (x3)
Macrophages and T-lymphocytes very important (unlike neutrophils in acute inflammatory response). T-lymphocytes can be cytotoxic. Plasma cells (develop from B-lymphocytes).
Where are macrophage names? (x3)
Bone marrow (where they originate) called monoblasts. Circulate in blood - called monocytes. Become macrophages when in tissues.
What are the actions of macrophages? (x4)
Phagocytosis (this would take them down the acute inflammatory response). Amplification of inflammation through cytokine release. This way, they control many other inflammatory cells. Wound repair and fibrosis (chronic). Each cycle of injury initiates another inflammatory response – hence why it is chronic. Anti-inflammatory effects (chronic). Dampen the pathogenic inflammatory response because they aim to repair things simultaneously.
What are the differences in outcomes of chronic inflammation when compared with acute infection? (x4)
SCARRING from necrosis more prominent in chronic infection. Formation of granulation tissue (new connective tissue) from attempted repair. No exudate in chronic inflammation. Loss of function much more common in chronic inflammation.
What does a chronic infection look like histologically?
Macrophages, lymphocytes and plasma cells will be abundant. Will see a granulation tissue – will look very loose and messy. Lots of cross-sections and fibroblasts.
1st picture is macrophage
2nd picture is lymphocyte
3rd picture is plasma cell

How do mediators differ between chronic and acute infections?
Acute – predominantly histamines. Chronic – predominantly cytokines.
What is granulomatous inflammation?
Subtype of chronic inflammation. Contains a granuloma. Granuloma is a cluster macrophages, triggered by a STRONG, specific T-lymphocyte reaction. It attempts to eliminate a RESISTANT offending agent, and does so my aggregating together (share nucleus).




